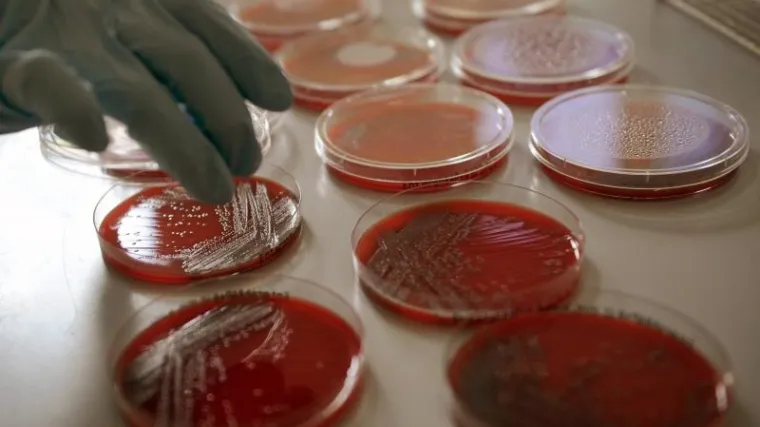
Smrtonosna zaraza poharala Europu

BURNE REAKCIJE /
Erika Kirk htjela poslati poruku mira, pa izazvala lavinu kritika
STOCKHOLM - Pedesetogodišnja žena, zaražena bakterijom Escherichijom coli prilikom boravka u Njemačkoj, preminula je u utorak u bolnici na jugozapadu Švedske. Ovo je prvi smrtni slučaj uzrokovan bakterijom Escherichijom coli izvan granica Njemačke.
Nakon Njemačke, gdje se broj smrtnih slučajeva popeo na petnaest, Švedska je druga zemlja u svijetu po broju zaraženih ovom opasnom bakterijom.
Najnoviji podaci govore od 39 zaraženih u Švedskoj, a kod 15 osoba su nastale ozbiljne komplikacije. Svi zaraženi nedavno su boravili u Njemačkoj.









